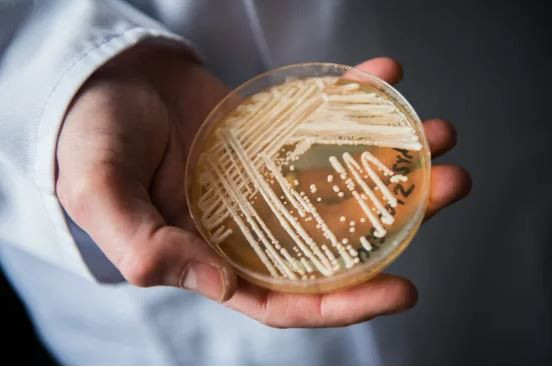
CDC Mỹ cảnh báo nguy cơ lây lan nhanh chóng của nấm Candida auris ảnh 1
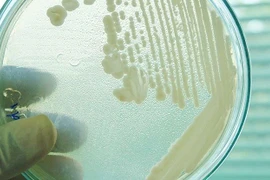
Nấm Candida auris. (Nguồn: Sciencealert)

Nấm Candida auris. (Nguồn: Getty Images)
Nấm Candida auris. (Nguồn: Getty Images)
Trung tâm Kiểm soát và Phòng ngừa dịch bệnh (CDC) Mỹ mới đây đã cảnh báo về xu hướng gia tăng và lây lan nhanh chóng của nấm Candida auris.
Theo báo cáo được công bố ngày 20/3, Candida auris bị xem là mối đe dọa kháng kháng sinh khẩn cấp (AR) do có thể chống lại nhiều loại thuốc chống nấm, dễ dàng lây lan trong các cơ sở y tế và có thể gây nhiễm trùng nặng với tỷ lệ tử vong cao.
[Hàng trăm người Mỹ nhiễm chủng nấm kháng thuốc Candida auris]
Dữ liệu của CDC cho thấy nấm Candida auris đã lây lan với tốc độ đáng báo động tại các cơ sở y tế Mỹ từ năm 2020-2021.
Một điều đáng lo ngại là vào năm 2021, số ca kháng với echinocandin - loại thuốc chống nấm được khuyên dùng nhiều nhất để điều trị Candida auris - đã tăng gấp ba lần.
CDC cho biết Candida auris không phải là mối đe dọa đối với những người khỏe mạnh. Tuy nhiên, những người bị bệnh nặng, sử dụng các thiết bị y tế xâm nhập, lưu lại các cơ sở chăm sóc sức khỏe thường xuyên hoặc trong thời gian dài sẽ có nguy cơ nhiễm nấm Candida auris cao hơn.
Tiến sỹ Meghan Lyman, nhà dịch tễ học của CDC, đã bày tỏ quan ngại về tình trạng gia tăng nhanh chóng và lây lan của các ca nhiễm Candida auris.
Bà nêu bật tầm quan trọng của việc tiếp tục giám sát, tăng cường năng lực phòng thí nghiệm, xét nghiệm chẩn đoán nhanh và tuân thủ các biện pháp phòng ngừa để ngăn chặn xu hướng lây lan hiện nay./.